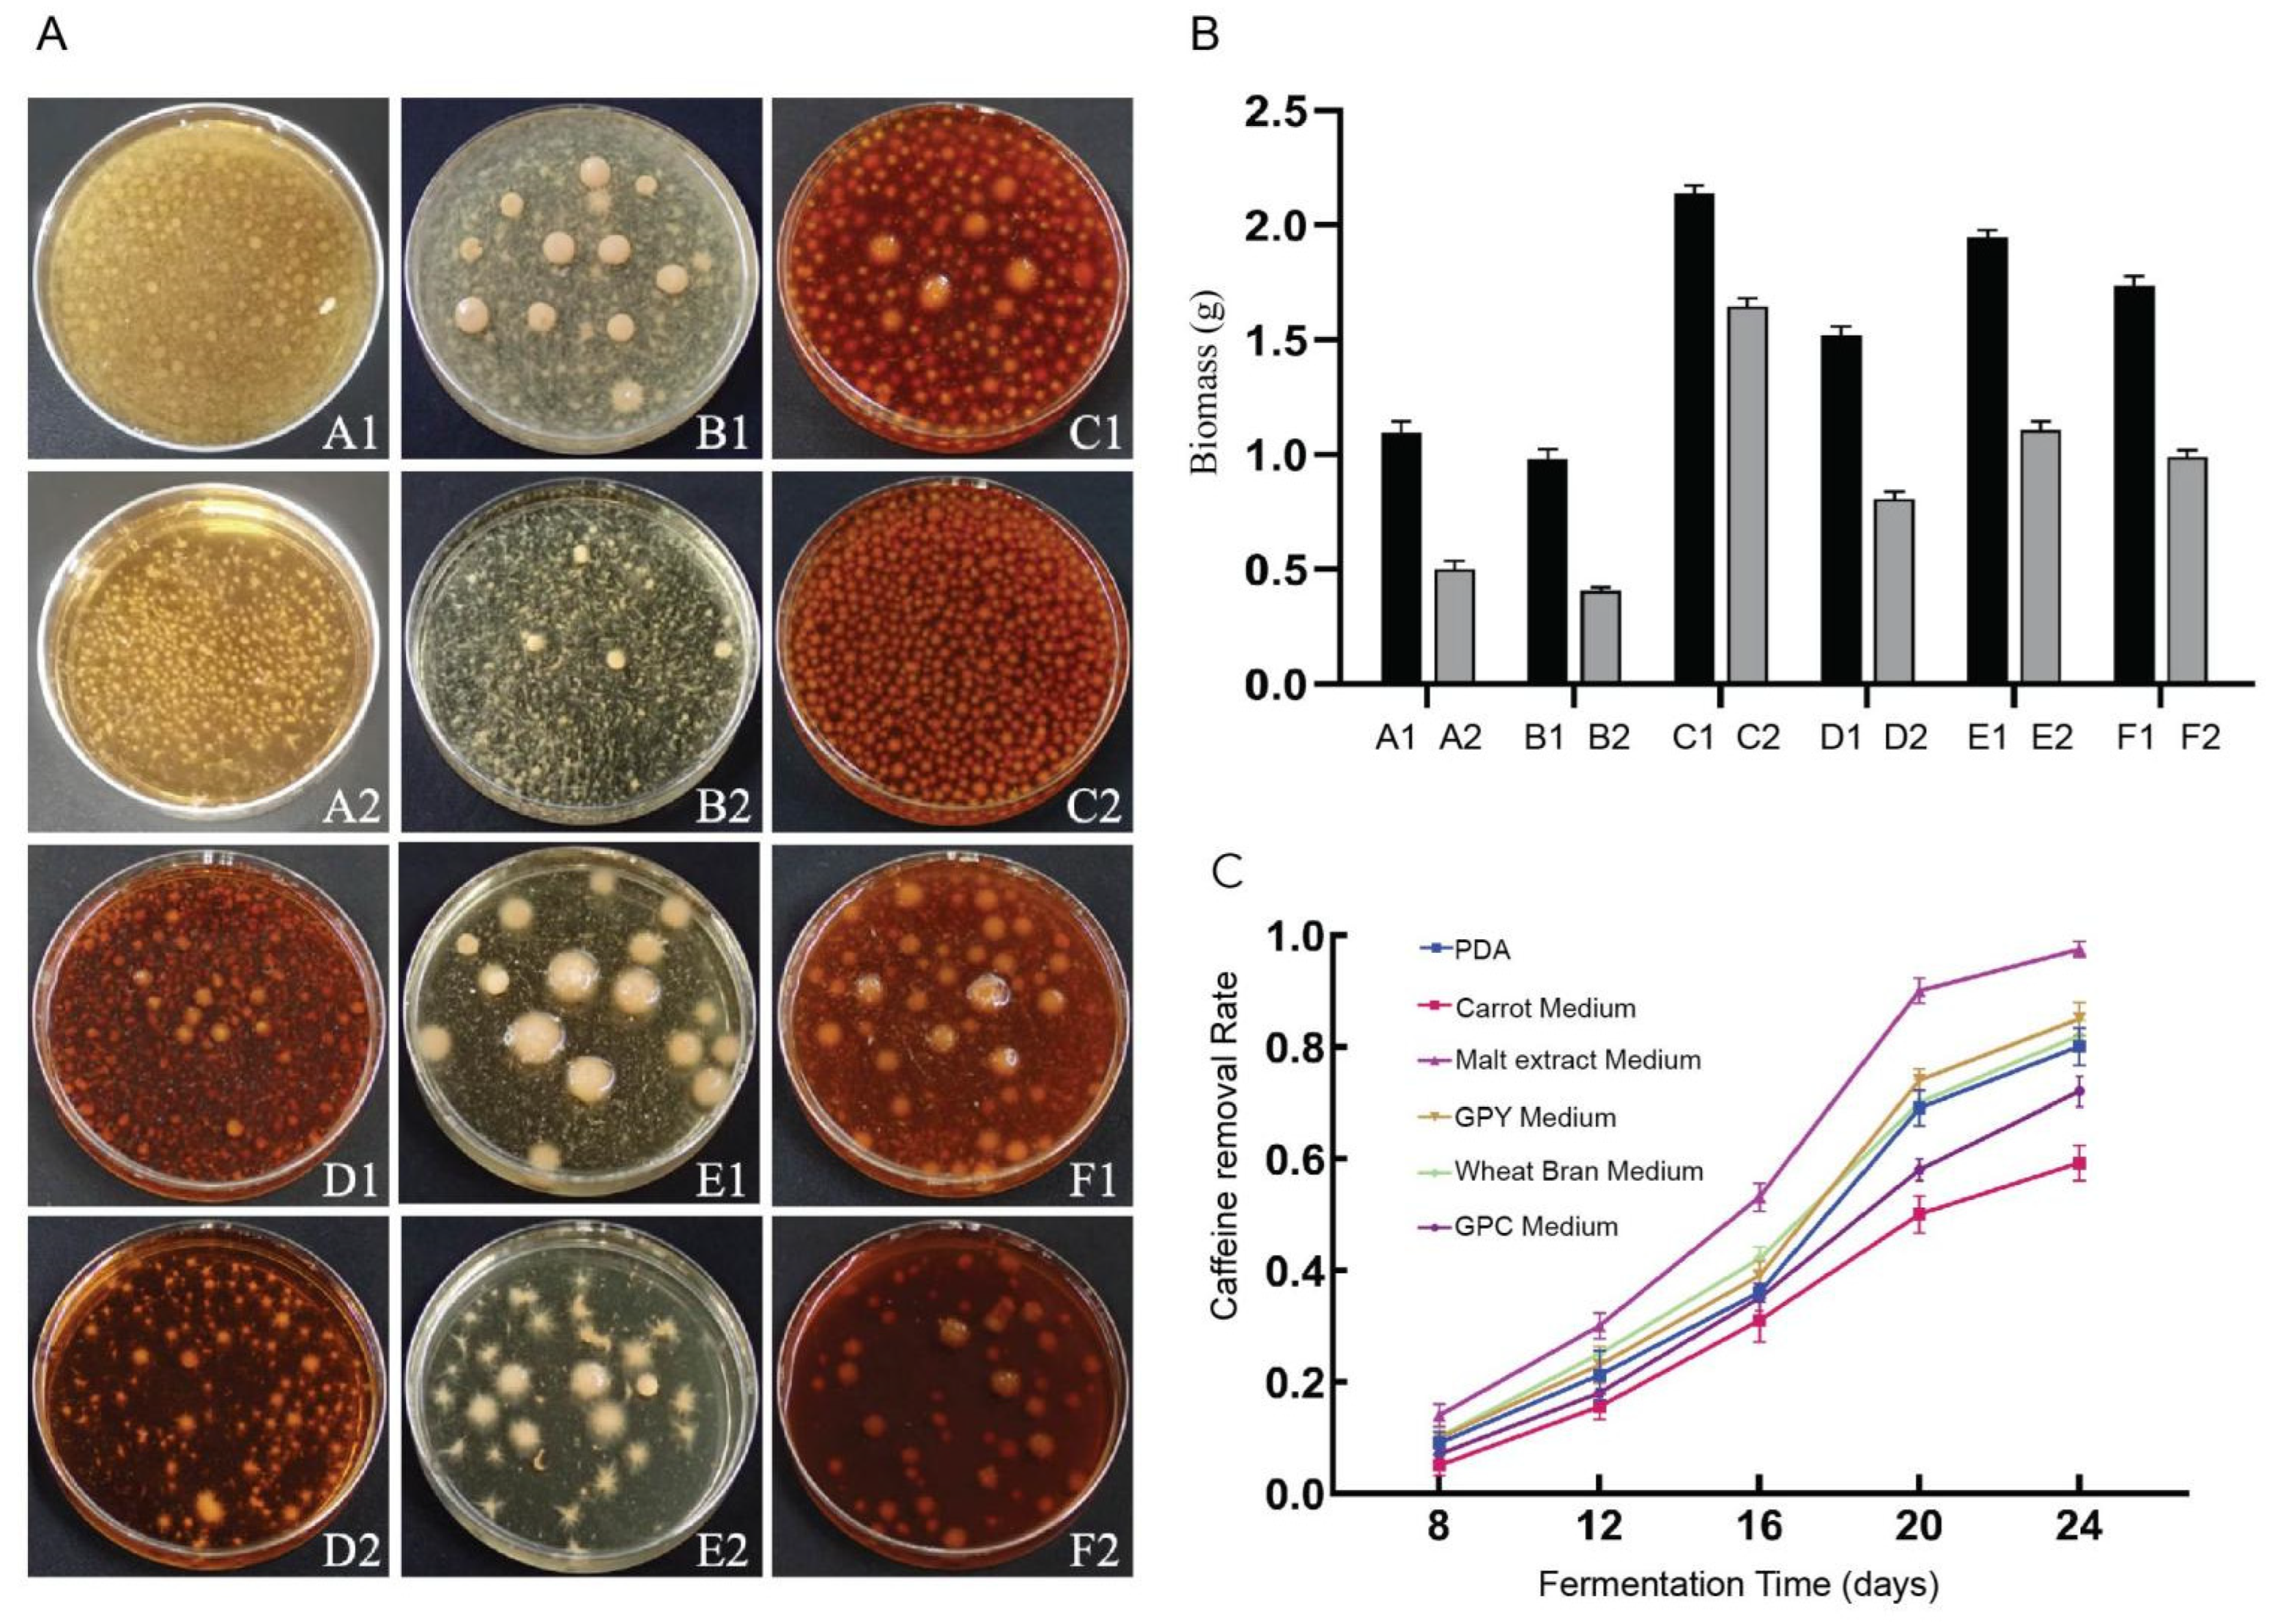
Microorganisms 13 02720 g002

Transcriptomic Insights into Caffeine Degradation Pathways in Desarmillaria tabescens
Abstract
1. Introduction
2. Materials and Methods
2.1. Screening and Preparation of Functional Strains for Caffeine Degradation
2.2. Optimization of Fermentation Conditions for Caffeine Degradation
2.3. Preparation of Fermentation Broth Samples
2.4. Sample Analysis
2.4.1. HPLC Analysis
2.4.2. Data Analysis
2.5. Preparation of RNA Sequencing Samples
2.6. RNA Extraction, Library Preparation, and Sequencing
2.7. Quality Control and Read Mapping
2.8. Differential Expression Analysis and Functional Enrichment
2.9. Time-Series Gene Expression Analysis
2.10. Secondary Metabolism Genes and Clusters Analysis
2.11. qRT-PCR Validation
3. Results
3.1. Compilation of Fungal Resources and Identification of Functional Strains Capable of Caffeine Degradation
3.2. Optimization of Degradation Conditions
3.2.1. Screening for the Optimal Culture Medium
3.2.2. Optimization of Caffeine Concentration Parameters
3.2.3. Optimization of Temperature Conditions
3.2.4. Optimization of pH Conditions
3.3. Analysis of HPLC Results
3.4. RNA-Seq Analysis
3.5. Functional Annotation, Classification, and Enrichment Analysis
3.6. Gene Expression Pattern Analysis of DEGs
3.7. Candidate Genes Involved in the Pathways
3.8. Secondary Metabolism, Energy, and Detoxification Under Caffeine Stress
3.9. Experimental Validation
4. Discussion
4.1. Branched Metabolic Network of Caffeine Degradation in D. tabescens
4.2. Physiological Significance of the “Stress-Degradation-Homeostasis” Three-Stage Transcriptional Regulation Model
4.3. Comparative Advantages of D. tabescens in Caffeine Degradation
5. Conclusions and Future Outlook
Supplementary Materials
Author Contributions
Funding
Institutional Review Board Statement
Informed Consent Statement
Data Availability Statement
Conflicts of Interest
References
- Higdon, J.V.; Frei, B. Coffee and Health: A Review of Recent Human Research. Crit. Rev. Food Sci. Nutr. 2006, 46, 101–123. [Google Scholar] [CrossRef]
- Ngueta, G. Caffeine and Caffeine Metabolites in Relation to Hypertension in U.S. Adults. Eur. J. Clin. Nutr. 2020, 74, 77–86. [Google Scholar] [CrossRef]
- Zhou, B.; Ma, C.; Xia, T.; Li, X.; Zheng, C.; Wu, T.; Liu, X. Isolation, characterization and application of theophylline-degrading Aspergillus fungi. Microb Cell Fact. 2020, 19, 72. [Google Scholar] [CrossRef] [PubMed]
- Thathola, P.; Agnihotri, V.; Pandey, A. Microbial Degradation of Caffeine Using Himalayan Psychrotolerant Pseudomonas sp.GBPI_Hb5 (MCC 3295). Curr. Microbiol. 2021, 78, 3924–3935. [Google Scholar] [CrossRef] [PubMed]
- Gutierrez, A.E.; Shah, P.; Rex, A.E.; Nguyen, T.C.; Kenkare, S.P.; Barrick, J.E.; Mishlera, D.M. Bioassay for Determining the Concentrations of Caffeine and Individual Methylxanthines in Complex Samples. Appl. Environ. Microbiol. 2019, 85, e01965-19. [Google Scholar] [CrossRef]
- Summers, R.M.; Mohanty, S.K.; Gopishetty, S.; Subramanian, M. Genetic Characterization of Caffeine Degradation by Bacteria and Its Potential Applications. Microb. Biotechnol. 2015, 8, 369–378. [Google Scholar] [CrossRef] [PubMed]
- Quandt, E.M.; Hammerling, M.J.; Summers, R.M.; Otoupal, P.B.; Slater, B.; Alnahhas, R.N.; Dasgupta, A.; Bachman, J.L.; Subramanian, M.V.; Barrick, J.E. Decaffeination and Measurement of Caffeine Content by Addicted Escherichia coli with a Refactored N-Demethylation Operon from Pseudomonas Putida CBB5. ACS Synth. Biol. 2013, 2, 301–307. [Google Scholar] [CrossRef]
- Summers, R.M.; Louie, T.M.; Yu, C.L.; Subramanian, M. Characterization of a Broad-Specificity Non-Haem Iron N-Demethylase from Pseudomonas Putida CBB5 Capable of Utilizing Several Purine Alkaloids as Sole Carbon and Nitrogen Source. Microbiology 2011, 157, 583–592. [Google Scholar] [CrossRef]
- Madyastha, K.M.; Sridhar, G.R. A Novel Pathway for the Metabolism of Caffeine by a Mixed Culture Consortium. Biochem. Biophys. Res. Commun. 1998, 249, 178–181. [Google Scholar] [CrossRef]
- Kim, J.H.; Kim, B.H.; Brooks, S.; Kang, S.Y.; Summers, R.M.; Song, H.K. Structural and Mechanistic Insights into Caffeine Degradation by the Bacterial N-Demethylase Complex. J. Mol. Biol. 2019, 431, 3647–3661. [Google Scholar] [CrossRef]
- Salmones, D.; Mata, G.; Waliszewski, K.N. Comparative Culturing of Pleurotus Spp. on Coffee Pulp and Wheat Straw: Biomass Production and Substrate Biodegradation. Bioresour. Technol. 2005, 96, 537–544. [Google Scholar] [CrossRef]
- Brand, D.; Pandey, A.; Roussos, S.; Soccol, C.R. Biological Detoxification of Coffee Husk by Filamentous Fungi Using a Solid State Fermentation System. Enzym. Microb. Technol. 2000, 27, 127–133. [Google Scholar] [CrossRef]
- Carrasco-Cabrera, C.P.; Bell, T.L.; Kertesz, M.A. Caffeine Metabolism during Cultivation of Oyster Mushroom (Pleurotus ostreatus) with Spent Coffee Grounds. Appl. Microbiol. Biotechnol. 2019, 103, 5831–5841. [Google Scholar] [CrossRef]
- Zhou, B.; Ma, C.; Ren, X.; Xia, T.; Li, X. LC-MS/MS-Based Metabolomic Analysis of Caffeine-Degrading Fungus Aspergillus sydowii during Tea Fermentation. J. Food Sci. 2020, 85, 477–485. [Google Scholar] [CrossRef]
- Dash, S.S.; Gummadi, S.N. Catabolic Pathways and Biotechnological Applications of Microbial Caffeine Degradation. Biotechnol. Lett. 2006, 28, 1993–2002. [Google Scholar] [CrossRef]
- Khan, M.F.; Rama, M.; Murphy, C.D. Biodegradation of Fluorinated β-Triketone Herbicide Tembotrione by a Bacterial–Fungal Consortium. Biocatal. Agric. Biotechnol. 2025, 70, 103828. [Google Scholar] [CrossRef]
- Khan, M.F.; Liao, J.; Liu, Z.; Chugh, G. Bacterial Cytochrome P450 Involvement in the Biodegradation of Fluorinated Pyrethroids. J. Xenobiotics 2025, 15, 58. [Google Scholar] [CrossRef]
- Esteves, F.; Rueff, J.; Kranendonk, M. The Central Role of Cytochrome P450 in Xenobiotic Metabolism—A Brief Review on a Fascinating Enzyme Family. J. Xenobiotics 2021, 11, 94–114. [Google Scholar] [CrossRef] [PubMed]
- Sipos, G.; Prasanna, A.N.; Walter, M.C.; O’Connor, E.; Bálint, B.; Krizsán, K.; Kiss, B.; Hess, J.; Varga, T.; Slot, J.; et al. Genome Expansion and Lineage-Specific Genetic Innovations in the Forest Pathogenic Fungi Armillaria. Nat. Ecol. Evol. 2017, 1, 1931–1941. [Google Scholar] [CrossRef] [PubMed]
- Fitri Faradilla, R.; Tamrin, T.; Nuh Ibrahim, M.; Rejeki, S.; Siala, A.; Firmansyah, F. Chemical, Mechanical, Antioxidant, and Antimicrobial Properties of Paper Prepared from Cocoa Bean Shell Using Polyethylene Glycol. J. Food Nutr. Res. 2019, 7, 579–583. [Google Scholar] [CrossRef]
- Ma, C.; Li, X.; Zheng, C.; Zhou, B.; Xu, C.; Xia, T. Comparison of Characteristic Components in Tea-Leaves Fermented by Aspergillus pallidofulvus PT-3, Aspergillus sesamicola PT-4 and Penicillium manginii PT-5 Using LC-MS Metabolomics and HPLC Analysis. Food Chem. 2021, 350, 129228. [Google Scholar] [CrossRef]
- Chen, S.; Zhou, Y.; Chen, Y.; Gu, J. fastp: An ultra-fast all-in-one FASTQ preprocessor. Bioinformatics 2018, 4, i884–i890. [Google Scholar] [CrossRef]
- Kim, D.; Langmead, B.; Salzberg, S. HISAT: A fast spliced aligner with low memory requirements. Nat. Methods 2015, 12, 357–360. [Google Scholar] [CrossRef]
- Pertea, M.; Pertea, G.; Antonescu, C.; Chang, T.-C.; Mendell, J.T.; Salzberg, S.L. StringTie enables improved reconstruction of a transcriptome from RNA-seq reads. Nat. Biotechnol. 2015, 33, 290–295. [Google Scholar] [CrossRef] [PubMed]
- Li, B.; Dewey, C.N. RSEM: Accurate Transcript Quantification from RNA-Seq Data with or without a Reference Genome. BMC Bioinform. 2011, 12, 323. [Google Scholar] [CrossRef] [PubMed]
- Wang, L.; Feng, Z.; Wang, X.; Wang, X.; Zhang, X. DEGseq: An R Package for Identifying Differentially Expressed Genes from RNA-Seq Data. Bioinformatics 2010, 26, 136–138. [Google Scholar] [CrossRef]
- Ernst, J.; Bar-Joseph, Z. STEM: A tool for the analysis of short time series gene expression data. BMC Bioinform. 2006, 7, 191. [Google Scholar] [CrossRef]
- Blin, K.; Shaw, S.; Vader, L.; Szenei, J.; Reitz, Z.L.; E Augustijn, H.; Cediel-Becerra, J.D.D.; de Crécy-Lagard, V.; A Koetsier, R.; E Williams, S.; et al. antiSMASH 8.0: Extended gene cluster detection capabilities and analyses of chemistry, enzymology, and regulation. Nucleic Acids Res. 2025, 53, 32–38. [Google Scholar] [CrossRef] [PubMed]
- Arocho, A.; Chen, B.; Ladanyi, M.; Pan, Q. Validation of the 2-DeltaDeltaCt Calculation as an Alternate Method of Data Analysis for Quantitative PCR of BCR-ABL P210 Transcripts. Diagn. Mol. Pathol. 2006, 15, 56–61. [Google Scholar] [CrossRef]
- Chen, P.; Song, J.; Guo, P.; Ji, R.Q. Biological characteristics of three Armillaria species from Northeast China and artificial cultivation of A. ostoyae. Mycosystema 2023, 42, 297–311. [Google Scholar] [CrossRef]
- Li, D. Cloning and Function Analysis of CYP82Ds Genes from Camellia sinensis. Doctoral Dissertation, Zhejiang University, Hangzhou, China, 2021. [Google Scholar]
- Kobetičová, K.; Nábělková, J.; Petříková, M.; Kočí, V.; Jerman, M.; Černý, R. Biodegradation of Methylxanthines by Coniophora puteana. AIP Conf. Proc. 2021, 2429, 020014. [Google Scholar] [CrossRef]
- He, C.; Huang, Y.; Liu, P.; Wei, J.; Yang, Y.; Xu, L.; Xiao, M. Transcriptome Analysis of Genes and Metabolic Pathways Associated with Nicotine Degradation in Aspergillus Oryzae 112822. BMC Genom. 2019, 20, 86. [Google Scholar] [CrossRef] [PubMed]
- Dave, B.; Moysa, E.L.; Kuźnik, A. Enhancing Fungal Adaptation for Efficient Caffeine Degradation in Wastewater: Biomimetic Approach and Environmental Optimization. Desalination Water Treat. 2025, 321, 100938. [Google Scholar] [CrossRef]
- Khan, M.F. Fungi for Sustainable Pharmaceutical Remediation: Enzymatic Innovations, Challenges, and Applications—A Review. Processes 2025, 13, 1034. [Google Scholar] [CrossRef]
- Ran, L.-X.; Wei, X.-Y.; Ren, E.-F.; Qin, J.-F.; Rasheed, U.; Chen, G.-L. Application of Microbial Fermentation in Caffeine Degradation and Flavor Modulation of Coffee Beans. Foods 2025, 14, 2606. [Google Scholar] [CrossRef] [PubMed]
- Khan, M.F.; Hof, C.; Niemcová, P.; Murphy, C.D. Recent Advances in Fungal Xenobiotic Metabolism: Enzymes and Applications. World J. Microbiol. Biotechnol. 2023, 39, 296. [Google Scholar] [CrossRef]

| Primer | Sequence (5′-3′) | Product Size (bp) |
|---|---|---|
| β_tub for | CTGGTTTCGCACCTTTGA | 241 bp |
| β_tub rev | TTGTTGGGAATCCACTCG | |
| DT_22397-F | TTGCGTTTCTTATTGCGGGATCAG | 75 bp |
| DT_22397-R | GCGTGCGTGCCAGGTAGTAG | |
| DT_14597-F | ATAGTGCGGCTGTGGCGAAG | 148 bp |
| DT_14597-R | GCTTCATCAGGATTCTCCAACACG | |
| DT_10255-F | GAATTGAAGGATGGAGTGGCAGAC | 138 bp |
| DT_10255-R | TAGAGGCAGGAAGGCGAAGTTG | |
| DT_13148-F | ACGGTTTCACACTCTCGCTTAATG | 132 bp |
| DT_13148-R | GCACATCAGATTCCACAGAGACATC | |
| DT_3381-F | CCGCATGTACGCAGTTATGTCAG | 119 bp |
| DT_3381-R | AGCCTTCCATCACGACCTGTC | |
| DT_9081-F | GGCGTCCTCTTCTCCGATAACC | 125 bp |
| DT_9081-R | GTGACATTGAGCGAAGCGAAGG | |
| DT_15188-F | ATGGTCTGGCGGGTCAAAGG | 101 bp |
| DT_15188_R | GCAAGTGTGGCGGATCGTAAC | |
| DT_18708-F | TTTCCCTTGCCTGCCTCCTC | 114 bp |
| DT_18708-R | GTCGTCGGTTCATCGCTTGG | |
| DT_3595-F | GCTTGTGCGGCTTACCTTCTAC | 86 bp |
| DT_3595-R | ATCCCTGTGACATGACCCTTGG | |
| DT_4877-F | GCTCTCAGTACCCGCCCTTTG | 87 bp |
| DT_4877-R | CGATCCGCCAGTCCGTTCTC | |
| DT_9523-F | GCAAGACCAACAGGATGGATACG | 116 bp |
| DT_9523-R | GCGGCGAAGCGAAGACATAG | |
| DT_9657-F | TGGCAACAACAGCAAGCAGAAG | 124 bp |
| DT_9657-R | GTGACCATCCGCTATACCTCCTAC |
Disclaimer/Publisher’s Note: The statements, opinions and data contained in all publications are solely those of the individual author(s) and contributor(s) and not of MDPI and/or the editor(s). MDPI and/or the editor(s) disclaim responsibility for any injury to people or property resulting from any ideas, methods, instructions or products referred to in the content. |
© 2025 by the authors. Licensee MDPI, Basel, Switzerland. This article is an open access article distributed under the terms and conditions of the Creative Commons Attribution (CC BY) license (https://creativecommons.org/licenses/by/4.0/).
Share and Cite
Wang, J.; Hu, Y.; Chang, Y.; Jiang, Y.; Meng, D.; Jiang, M.; Wang, J.; Shen, P. Transcriptomic Insights into Caffeine Degradation Pathways in Desarmillaria tabescens. Microorganisms 2025, 13, 2720. https://doi.org/10.3390/microorganisms13122720
Wang J, Hu Y, Chang Y, Jiang Y, Meng D, Jiang M, Wang J, Shen P. Transcriptomic Insights into Caffeine Degradation Pathways in Desarmillaria tabescens. Microorganisms. 2025; 13(12):2720. https://doi.org/10.3390/microorganisms13122720
Chicago/Turabian StyleWang, Junrui, Yongqiang Hu, Yuxin Chang, Yiguo Jiang, Danping Meng, Mingguo Jiang, Jinzi Wang, and Peihong Shen. 2025. "Transcriptomic Insights into Caffeine Degradation Pathways in Desarmillaria tabescens" Microorganisms 13, no. 12: 2720. https://doi.org/10.3390/microorganisms13122720
APA StyleWang, J., Hu, Y., Chang, Y., Jiang, Y., Meng, D., Jiang, M., Wang, J., & Shen, P. (2025). Transcriptomic Insights into Caffeine Degradation Pathways in Desarmillaria tabescens. Microorganisms, 13(12), 2720. https://doi.org/10.3390/microorganisms13122720

